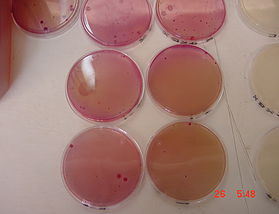
image
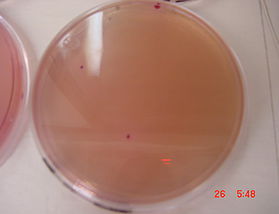
image

Control de calidad
Nuestra empresa cuenta con un departamento de control de calidad, para asegurar el lineal procesamiento de los diferentes productos que ésta produce, evaluando sistemáticamente y de acuerdo a la reglamentación existente, tanto a productos, como al personal involucrado en el proceso.